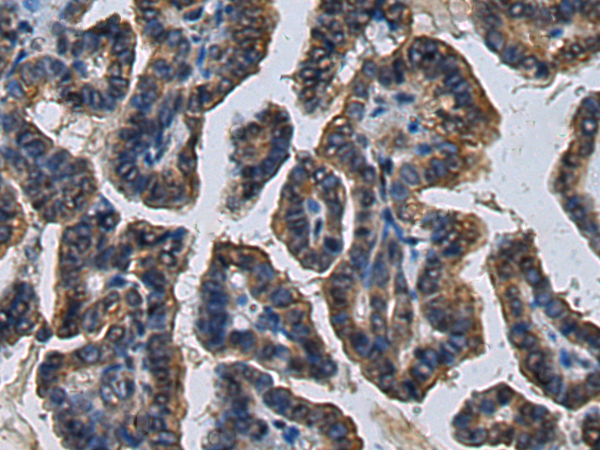

|
Background: |
This protein encoded by this gene transfers sulfate to the C-3 hydroxyl of terminal glucuronic acid of protein- and lipid-linked oligosaccharides. This protein was first identified as a sulfotransferase that acts on the human natural killer-1 (HNK-1) glycan; HNK-1 is a carbohydrate involved in neurodevelopment and synaptic plasticity. |
|
Applications: |
ELISA, WB, IHC |
|
Name of antibody: |
CHST10 |
|
Immunogen: |
Fusion protein of human CHST10 |
|
Full name: |
carbohydrate sulfotransferase 10 |
|
Synonyms: |
HNK1ST; HNK-1ST |
|
SwissProt: |
O43529 |
|
ELISA Recommended dilution: |
5000-10000 |
|
IHC positive control: |
Human liver cancer and Human thyroid cancer |
|
IHC Recommend dilution: |
100-300 |
|
WB Predicted band size: |
42 kDa |
|
WB Positive control: |
PC-3 cell lysate |
|
WB Recommended dilution: |
500-2000 |

購物車
幫助
021-54845833/15800441009
